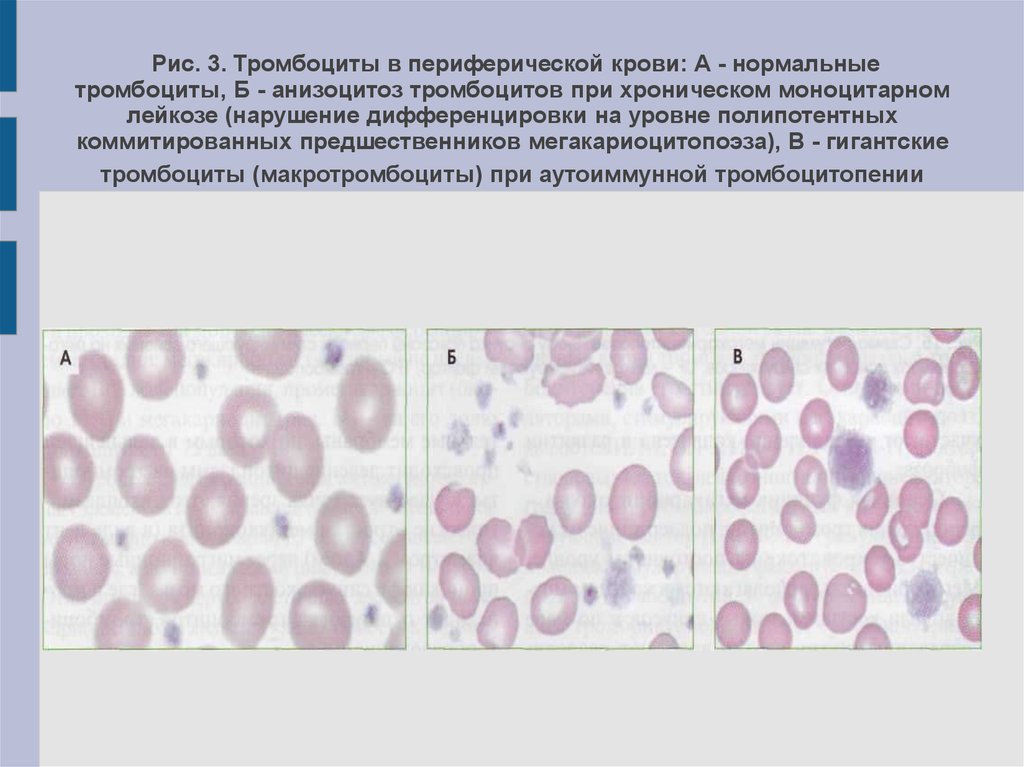

Смешанный анизоцитоз с преобладанием микроцитов
The dark pictures стим
Legend tool
Кушают ли ежей
Vita устройство
Командная работа в управлении
Настройка брандмауэра яндекса
Включи 2 не 3
Эдисон новое видео сбежал от родителей
Сказка про задачи
Трабл на английском
Блокс фрутс лео
Клуб кому за казань
Нмо ответы тест мужское бесплодие с ответами
Смешанный анизоцитоз с преобладанием микроцитов 109 фото